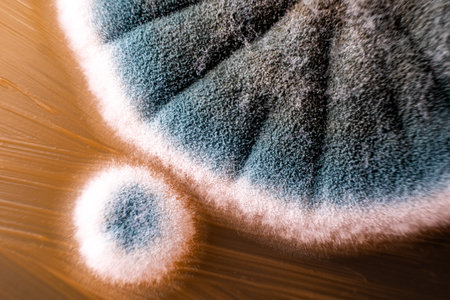
Close-up of mold growth with blue and white textures on a surface.の写真素材

写真素材 - Close-up of mold growth with blue and white textures on a surface.
作品情報
Close-up of mold growth with blue and white textures on a surface.
- ID:253370773
- 作品種別:写真
- 作者名:Mohammed Alali
キーワード
- abstract
- biological process
- biology
- biology experiment
- biology study
- blue
- close-up
- decay
- decline
- decomposition
- detail
- environment
- environmental science
- fungal growth
- fungi
- fungus
- growth
- laboratory
- macro
- microbial growth
- microbiology
- microorganism
- mold
- moldy surface
- natural
- natural phenomenon
- nature
- organic
- organic matter
- pattern
- petri dish
- research
- science
- scientific observation
- scientific study
- society
- spores
- surface
- texture
- white
類似作品
Blurred backgro...
Shot of mold on...
A stunning clos...
An enchanting c...
Mold close-up m...
Bacteria microo...
Close up of mol...
Aspergillus (mo...
A detailed micr...
Fungus on old c...
Fungus on old c...
green yellow ro...
Yellow fungus ...
mold on pickled...
Backgrounds of ...
Mushroom cultiv...
Penicillium, as...
microbiology ba...
Grunge wall. Us...
Fungi culture o...
A close up of a...
Aspergillus (mo...
Close up white ...
Green mould bac...
Psilocybin mush...
Fungus on old c...
macro of mold r...
Backgrounds of ...
Pumpkin covered...
Close-up view r...
Closeup of Mold...
Mold close-up m...
mold in orange ...
A macro close-u...
macro of mold r...
A close-up view...
Close-up on tex...
Abstract gold s...
mold on eggplan...
spread of green...
Microscopic Sil...
Fluffy gray mol...
Fungus on old c...
green yellow ro...
close-up of a g...
Close up of mol...
mold on juice, ...
Mold close-up m...
microbiology ba...